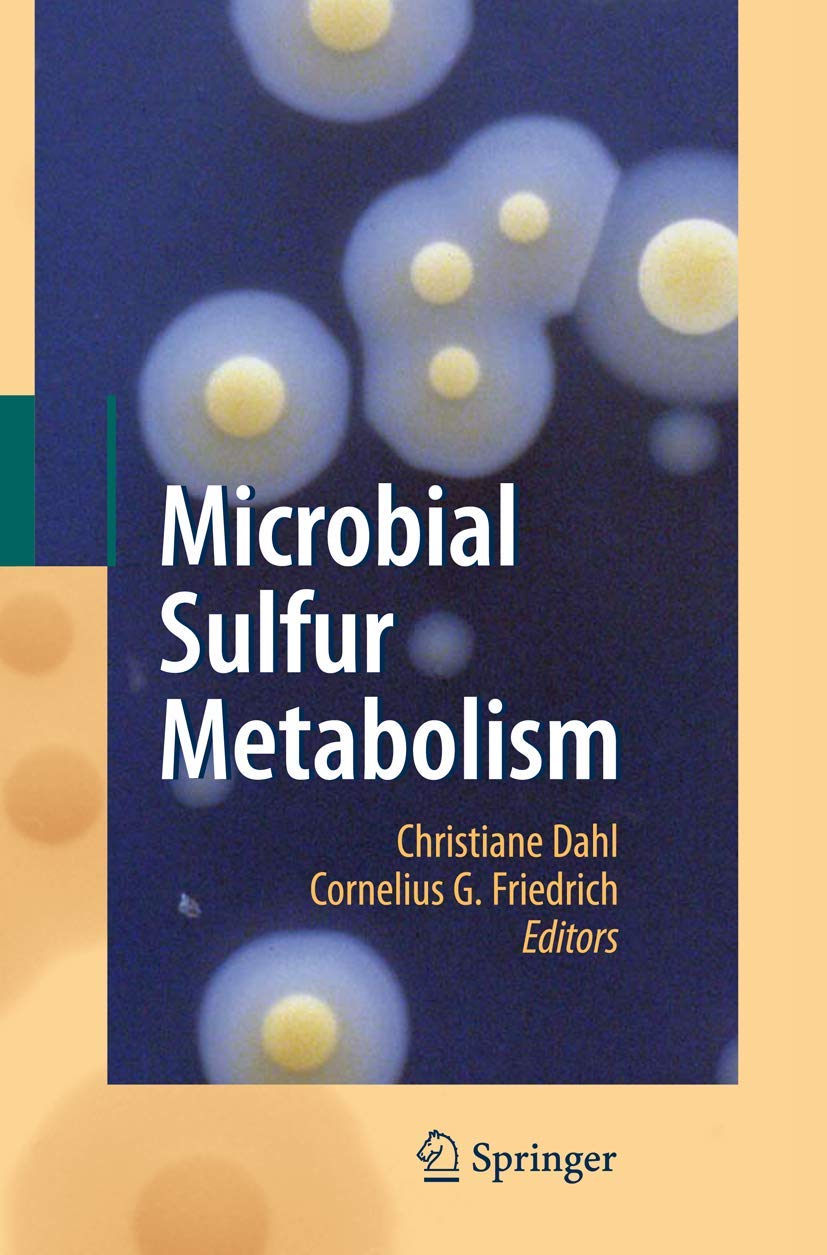

Microbial Sulfur Metabolism
Microbial Sulfur Metabolism is backordered and will ship as soon as it is back in stock.
Couldn't load pickup availability
Genuine Products Guarantee
Genuine Products Guarantee
We guarantee 100% genuine products, and if proven otherwise, we will compensate you with 10 times the product's cost.
Delivery and Shipping
Delivery and Shipping
Products are generally ready for dispatch within 1 day and typically reach you in 3 to 5 days.
Author: Dahl, Christiane
Brand: Springer
Edition: 2008 ed.
Binding: hardcover
Format: Illustrated
Number Of Pages: 308
Release Date: 04-12-2007
Part Number: 27 black & white tables, biography
EAN: 9783540726791
Package Dimensions: 9.2 x 6.3 x 0.7 inches
Languages: English